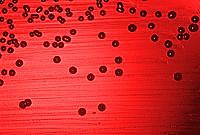
se secuencia el primer genoma completo de un organismo celular

-
Mendel experimenta con realizar un entrecruzamiento con guisantes con parte de otras semillas y luego de tantos años de investigación formulo sus leyes que luego serian conocidas como las 3 leyes mendelianas
-
Mendel decide publicar todo lo que había descubierto en sus años de experimentación
-
Morgan se intereso por el dilema de la herencia biológica, por lo que lo estudio hasta su muerte
-
16 años luego de la muerte de Mendel, el mundo científico se interesa por la obra de Mendel
-
Archibald Garrod publicó sus resultados sobre alcaptonúricos, demostrando que en la orina de estos individuos había gran cantidad de ácido homogentísico, un producto del metabolismo de los aminoácidos (abreviado: aa) tirosina y fenilalanina, que normalmente no se encuentra en la orina.
-
el británico William Bateson acuño este termino para designar "la ciencia dedicada al estudio de los fenómenos de la herencia y de la variación"
-
establece que en una población suficientemente grande, en la que los apareamientos se producen al azar y que no se encuentra sometida a mutación, selección o migración, las frecuencias génicas y genotípcas se mantienen constantes de una generación a otra, una vez alcanzado un estado de equilibrio que en loci autosómicos se alcanza tras una generación.
-
Morgan analizó las características de la mosca de la fruta. Se compone de dos líneas "puras".Una de estas líneas presenta el fenotipo "silvestre" con los ojos rojos y el otro, el fenotipo "mutante" con ojos blancos.
Afirmó que el 100% de los descendientes de F₁ presenta el fenotipo de tipo silvestre. Una de las dos características parentales ha desaparecido. Se deduce que el alelo mutante (w) del gen responsable del color de ojos es recesivo, y el alelo de tipo salvaje (W⁺) es dominante. -
el danés Wilhelm Johannsen introduce el término gen útil como expresión para los factores unitarios, que se ha demostrado que están en los gametos por los investigadores modernos del mendelismo".
-
Los estudios comandados por Thomas Hunt Morgan descubren la herencia ligada al X y la base cromosómica del ligamiento
-
Alfred Henry Sturtevant, socio de Morgan, al observar el desarrollo de las moscas en el que la división celular temprana produce dos genomas diferentes, midió la distancia embrionaria entre los órganos en una unidad que se llama la sturt en su honor.
-
Calvin Bridges, estudiante de Morgan, como se indicó anteriormente, las hembras de Drosophila de ojos blancos cruzadas con machos de ojos rojos generalmente producen progenie de ojos rojos y hembras de ojos blancos. Entre miles de tales descendientes "regulares", ocasionalmente se encuentran hembras de ojos blancos y machos de ojos rojos excepcionales.
-
Ronald Fisher demostró esto gracias a que integro el mendelismo con la biometría.
-
En 1928, llevó a cabo una serie de experimentos con ratones y bacterias.El no intentaba identificar el material genético, sino en realidad trataba de desarrollar una vacuna contra la neumonía. En sus experimentos, Griffith utilizó dos cepas, conocidas como R y S. Griffith concluyó que las bacterias de la cepa R debían haber tomado lo que él llamó "principio transformante" de las bacterias S muertas por calor, que les permitió "transformarse" en bacterias con cobertura lisa y volverse virulentas.
-
Se demostró esto de 2 maneras diferentes, la primera Harriet Creighton y Barbara McClintock en el maíz y la segunda Gunter Stern en Drosophila. Todos estos descubrimientos condujeron a la fundación conceptual de la Genética clásica.
-
La hipótesis un gen, una enzima establece que cada gen codifica una sola enzima.Beadle y Tatum confirmaron la hipótesis de Garrod con estudios genéticos y bioquímicos del moho del pan
-
La conjunción entre el interés sobre la genética más los resultados de la genética microbiana. Esto fue demostrado por el medico Oswald T. Avery junto a C. M.
MacLeod y Maclyn McCarty. -
Se confirma el ADN como material genetico y no como proteínas como se pensaba en la época
-
En el laboratorio dirigido por el físico J.T.Randall, King’s College,en Londres, se hicieron los más detallados y precisos estudios de difracción de rayos X de muestras de ADN, hechos por la joven física británica Rosalind Franklin
-
James Watson y Francis Crick descubrieron esto luego de hacer modelos fallidos, y un día se cambiaron las ubicaciones, y entonces encontramos el apareamiento de bases,
-
Ellos demostraron que cada cadena de una molécula de ADN sirve como molde para la síntesis de una nueva cadena complementario abriendo una puerta para el problema de como la secuencia del ARN se traduce en secuencia proteica se empieza a resolver
-
Las bases nitrogenadas que forman normalmente parte del ADN son: Adenina (A), Guanina (G),
Citosina y Timina (T). Las bases nitrogenadas que forman parte de el ARN son: Adenina (A),
Guanina (G), Citosina (C) y Uracilo (U). Por tanto, la Timina es específica del ADN y el Uracilo es
específico del ARN. -
Ellos probaron que este código requiere tres unidades de ADN para montar cada uno de los aminoácidos, los ladrillos con los que se fabrican las proteínas
-
François Jacob y Jacques Monod propusieron el modelo del operón como mecanismo de regulación de la expresión génica en procariotas.
-
Charles Yanofsky y sus ayudantes localizaron una serie de mutaciones en el gen que codifica una enzima necesaria para la síntesis
-
Con microscopia electrónica se pudo demostrar que la molécula de ADN es muy larga, de una anchura constante (de 23 nm), señalada entre las dos líneas, y además que es flexible y esto le permite curvarse
-
Estos científicos ademas averiguaron que la secuencia de ARN UUU codifica el aminoácido fenilalanin, dando pista para desvelar 4 años después el código genético completo
-
Realizaron un estudio de la variación alozímica de las poblaciones naturales, obteniéndose las primeras estimas de la variación genética de un sin número de especies.
-
La técnica permite editar el ADN de un ser vivo de forma rapidísima, abriendo vía a la ingeniera genética
-
la primera endonucleasa de restricción, la K12 en E coli. Cortaba fragmentos largos y concretos, por lo que se pensó que reconocía secuencias específicas del DNA. Se abandonó porque aunque reconocía una zona determinada del DNA, cortaba al DNA a varias Kb de distancia
-
La primera molécula de ADN recombinante, con la unión de trozos de ADN de especies diferentes, fue obtenida por Paul Berg y Peter Lobban, de forma independiente.
-
-
-
El primer animal modificado genéticamente o transgénico fue un ratón. Dos años después, los investigadores introdujeron en ratones el gen de la hormona de crecimiento de rata
-
además del splicing que ocurre normalmente en el núcleo de células eucariotas y produce mRNA maduro, otro grupo de RNA sufre un tipo de splicing todavía más espectacular. Este tipo de mecanismo, la autocatálisis del RNA, fue observado por primera vez cuando estudiaban al protista unicelular Tetrahymena y uno de sus RNA ribosómicos
-
-
Ésta es una metodología basada en el análisis de regresión múltiple que permite separar, al menos en teoría, de un conjunto de caracteres correlacionados, aquellos caracteres que son seleccionados directamente (es decir, aquellos que son adaptativos) de los que no lo son.
-
(PCR por sus siglas en inglés). El proceso fue descrito originalmente por Kjell Kleppe y el nobel de 1968 Har Gobind Khorana, que permite la amplificación de secuencias específicas de ADN. Las mejoras hechas por Mullis permitieron convertir a la PCR en una técnica central en bioquímica y biología molecular
-
La fibrosis quística es una enfermedad genética de herencia autosómica recesiva, caracterizada por disfunción de las glándulas de secreción exocrina.
-
Watson y otros científicos se interesan por este proyecto del genoma humano para cartografiar completamente el genoma humano y, finalmente, determinar su secuencia de bases
-
Este organismo fue Haemophilus influenzae.
-
se obtiene en el laboratorio de I. Wilmut el primer mamífero clónico obtenido a partir de células mamarias diferenciadas.
-
La consecuencia inmediata de completar la secuenciación del genoma humano es que se dispone de la secuencia de los 3.000 millones de bases nitrogenadas que constituyen en ADN humano. Esas tres mil Mb (abreviación de millón de bases) están distribuidas en los 23 pares de cromosomas humanos, proporcionalmente al tamaño de cada uno de éstos; de manera que, el cromosoma 21, que es el más pequeño,tiene un ADN con aproximadamente 41 Mb, y el 22 tiene 45 de las cuales 33,4 Mb fueron secuenciadas
-
Recientemente, dos expertos en genética, han planteado que se debería empezar a secuenciar el genoma de los pacientes con COVID-19.Los investigadores señalan que podría haber diferencias genéticas entre los pacientes que desarrollan las formas más graves de la enfermedad y aquellos que muestran síntomas más leves.
Existen múltiples factores que influyen en la sensibilidad a la infección por el virus. Uno de ellos es la edad, que afecta ante todo el sistema inmunitario para defender al organismo.
A list shows items. A timeline shows sequence.
Use Timetoast to make dates, milestones, and turning points easier to understand in a clear visual format. Timetoast is a timeline maker for work, school, research, and stories.